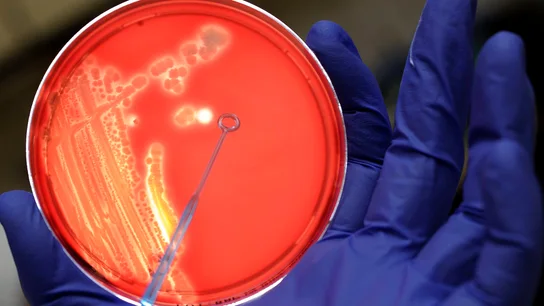
Diseñan una 'bomba genética programable' capaz de matar solo bacterias malas Diseñan una 'bomba genética programable' capaz de matar solo bacterias malas
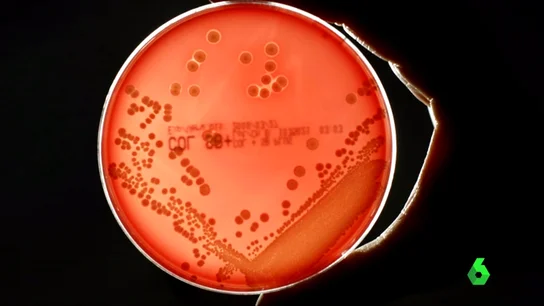
Frame 28.520143 de: ANTIBIOTICOS Frame 28.520143 de: ANTIBIOTICOS

EMBRIAGUEZ CONSTANTE

EMBRIAGUEZ CONSTANTE

OPTARON POR TRATARLE CON HOMEOPATÍA

PARA 2050

LAS BACTERIAS PODRÍAN VOLVERSE RESISTENTES
GRACIAS A CIENTÍFICOS ESPAÑOLES Y FRANCESES

EL PRIMER CASO SE REGISTRÓ EN 2009

LOS ENSAYOS CON HUMANOS SERÁN EN 2020

HAN GENERADO 670.000 INFECCIONES ESTE AÑO

SEGÚN LA INVESTIGACIÓN DE CIENTÍFICOS ESTADOUNIDENSES

LLEVAMOS AÑOS SIN DESARROLLAR ANTIBIÓTICOS PARA ALGUNAS ENFERMEDADES
LLEVAMOS AÑOS SIN DESARROLLAR ANTIBIÓTICOS PARA ALGUNAS ENFERMEDADES

LA PRIMERA EN LA LISTA DE SUPERBACTERIAS

LA PRIMERA EN LA LISTA DE SUPERBACTERIAS

SE TRATA DE UNA INFECCIÓN DE TRANSMISIÓN SEXUAL

EN ESTADOS UNIDOS

ESTUDIO REALIZADO EN NIÑOS DE ENTRE 0 Y 18 AÑOS

ÚLTIMO INFORME DEL CIS